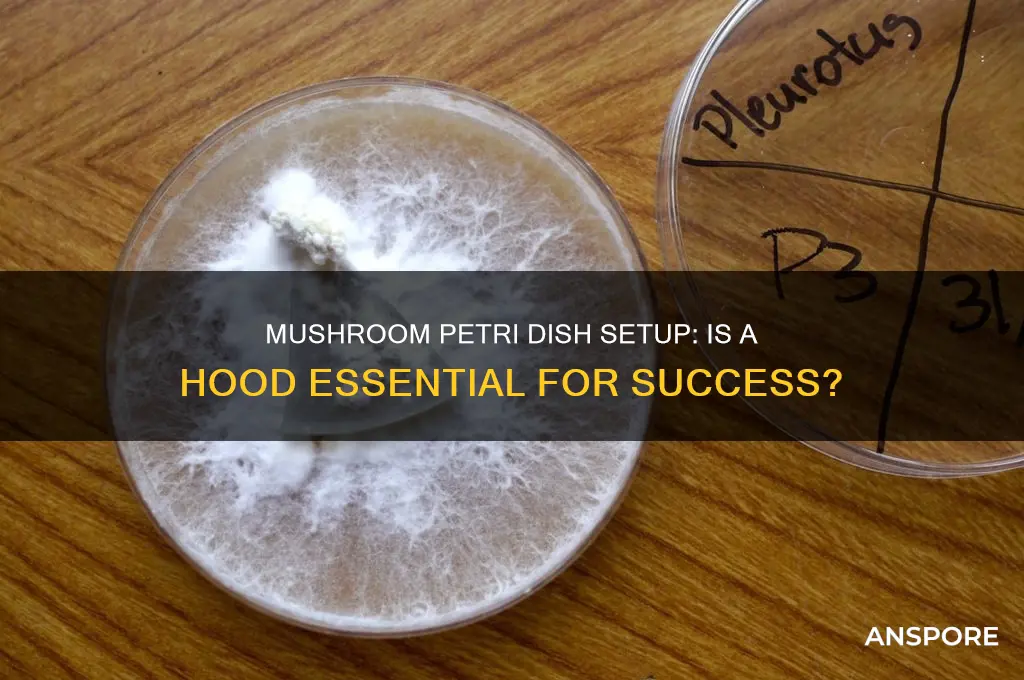
do i need a hood for creating mushroom petri dishes

When creating mushroom petri dishes, the question of whether a hood is necessary often arises, especially for beginners. A hood, typically a laminar flow hood or still air box, is designed to provide a sterile environment by filtering out airborne contaminants. While it significantly reduces the risk of contamination, it is not always mandatory for small-scale or hobbyist projects. However, without a hood, maintaining sterility becomes more challenging, as even minor airborne particles or spores can compromise the culture. For those serious about successful and consistent results, investing in a hood is highly recommended, but alternatives like working in a clean, draft-free area with proper sterilization techniques can sometimes suffice for less critical applications.
| Characteristics | Values |
|---|---|
| Necessity of a Hood | Not strictly required, but highly recommended for sterility. |
| Purpose of a Hood | Creates a sterile environment to prevent contamination during inoculation. |
| Alternatives to a Hood | Still air box, DIY laminar flow hood, or working in a clean, draft-free area with proper sterilization techniques. |
| Contamination Risk Without a Hood | Higher risk due to airborne particles and lack of sterile airflow. |
| Cost of a Hood | Varies; DIY options are affordable, while professional models can be expensive. |
| Skill Level Required | Basic to intermediate, depending on the method used. |
| Success Rate Without a Hood | Lower compared to using a hood, but possible with meticulous technique. |
| Recommended for Beginners | Yes, if using a still air box or DIY hood; otherwise, practice is key. |
| Time Investment | Minimal with a hood; more time-consuming without due to potential retries. |
| Sterility Assurance | High with a hood; moderate to low without, depending on technique. |
Explore related products
$188
What You'll Learn

Sterile Environment Importance
When creating mushroom petri dishes, maintaining a sterile environment is paramount to the success of the cultivation process. Contamination from bacteria, mold, or other microorganisms can quickly ruin your cultures, leading to wasted time, resources, and effort. The primary purpose of a sterile environment is to eliminate competing organisms that could outgrow your mushroom mycelium, ensuring that only the desired fungus thrives. Without proper sterility, even the most carefully prepared petri dishes can become breeding grounds for unwanted microbes, jeopardizing your entire project.
A hood, specifically a laminar flow hood, plays a critical role in achieving and maintaining sterility. It creates a controlled environment by filtering airborne particles and providing a clean workspace. The hood’s HEPA filter removes dust, spores, and other contaminants from the air, directing a steady stream of sterile air over your work area. This minimizes the risk of airborne contamination, which is a common issue when working with delicate cultures like mushroom mycelium. While it is technically possible to create mushroom petri dishes without a hood, the risk of contamination increases significantly, especially for beginners or in less-controlled environments.
The importance of a sterile environment extends beyond just the physical workspace. Proper techniques, such as flame sterilization of tools and thorough hand hygiene, are equally essential. However, these practices are most effective when combined with a hood, as it provides an additional layer of protection against environmental contaminants. Without a hood, even minor lapses in technique can introduce contaminants that are difficult to detect until it’s too late. For serious cultivators, investing in a laminar flow hood is a practical step toward ensuring consistent and reliable results.
For those who cannot access a hood, alternative methods like the "glove box" technique or working in a still air box can help reduce contamination risks. However, these methods are less effective than a hood and require meticulous attention to detail. The still air box, for instance, relies on creating a sealed environment, but it lacks the continuous flow of filtered air that a hood provides. Ultimately, while these alternatives can work in a pinch, they are not substitutes for the reliability and efficiency of a laminar flow hood.
In conclusion, the importance of a sterile environment in creating mushroom petri dishes cannot be overstated. A laminar flow hood is a valuable tool that significantly reduces the risk of contamination, ensuring the success of your cultures. While it is possible to work without one, the challenges and risks involved make it a worthwhile investment for anyone serious about mushroom cultivation. Prioritizing sterility through the use of a hood and proper techniques will save time, resources, and frustration, ultimately leading to healthier and more productive mycelium cultures.
Mushroom Trips: What's the After-Effect?
You may want to see also

Hood vs. DIY Alternatives
When creating mushroom petri dishes, the question of whether a hood is necessary often arises, especially for beginners. A laminar flow hood is a professional-grade tool designed to create a sterile environment by filtering air and directing it downward, minimizing contamination. It’s highly effective but comes with a significant cost, ranging from $200 to $1,000 or more, depending on size and features. For serious cultivators or those working with sensitive strains, a hood is a reliable investment. However, it may be overkill for casual hobbyists or those just starting out.
For those looking to save money or prefer a hands-on approach, DIY alternatives can be surprisingly effective. One popular method is the Still Air Box (SAB), which is a simple enclosure made from materials like plastic storage bins, acrylic sheets, or even cardboard. By working inside the box with minimal movement and using alcohol to sanitize hands and tools, you can create a relatively sterile environment. Another DIY option is the Glove Box, which adds gloves attached to the box to minimize contact with the internal environment. These alternatives are budget-friendly, often costing less than $50, and can yield successful results with careful technique.
The choice between a hood and DIY alternatives largely depends on your goals, budget, and level of commitment. A hood provides a higher level of sterility and consistency, making it ideal for advanced cultivators or those working with delicate mushroom strains. However, it requires a larger initial investment and space. DIY methods, while more affordable and accessible, demand greater attention to detail and patience. Contamination risks are higher, but with practice, many cultivators achieve success without a hood.
Another factor to consider is the scale of your operation. If you’re producing petri dishes in large quantities or for commercial purposes, a hood becomes more justifiable due to its efficiency and reliability. For small-scale or experimental projects, DIY alternatives are often sufficient. Additionally, combining DIY methods with good sterile technique, such as using a flame from an alcohol burner to sterilize tools, can significantly improve success rates without the need for a hood.
Ultimately, the decision to use a hood or DIY alternative comes down to balancing cost, convenience, and desired outcomes. If you’re new to mushroom cultivation, starting with a DIY setup allows you to gain experience and determine whether investing in a hood is worthwhile. For those with higher stakes or a need for precision, a hood offers peace of mind and a higher success rate. Whichever path you choose, understanding the pros and cons of each option will help you make an informed decision tailored to your needs.
Mushroom 11: Exploring the Chapters
You may want to see also

Cost-Effective Solutions
When creating mushroom petri dishes, a sterile environment is crucial to prevent contamination. While a laminar flow hood is the gold standard for maintaining sterility, it can be expensive and may not be feasible for hobbyists or those on a tight budget. Fortunately, there are several cost-effective solutions to achieve a sterile environment without breaking the bank. One of the most accessible methods is the glove box technique, which involves using a clear plastic container with gloves attached to the sides. This DIY setup allows you to work in a confined, sterile space by sterilizing the interior with alcohol or a disinfectant and maintaining a closed environment while inoculating your petri dishes.
Another budget-friendly option is the still-air box, which is essentially a large, clear container with an open top. To use this method, you sterilize the interior and your hands with alcohol, then work quickly and carefully to minimize the risk of contamination. While not as effective as a laminar flow hood, this approach can yield good results if you practice proper sterile technique, such as flaming your inoculation loop and working near an open flame to create a convection current that pushes contaminants away. This method requires patience and precision but is highly cost-effective, as it uses materials you may already have or can easily acquire.
For those willing to invest a little more but still stay within a modest budget, a HEPA filter box can be a great middle-ground solution. By attaching a HEPA filter to a DIY box with a fan, you can create a makeshift laminar flow hood that pushes sterile air over your workspace. While this setup won’t match the efficiency of a professional hood, it significantly reduces the risk of contamination compared to working in open air. You can find affordable HEPA filters and fans online, making this a viable option for those who want better protection without the high cost of a commercial unit.
If you’re looking for an even simpler and cheaper solution, consider the pressure cooker sterilization method combined with working in a clean environment. Sterilize your petri dishes and tools in a pressure cooker, then work in a room with minimal airflow, such as a bathroom with the windows closed. Wipe down surfaces with alcohol, wear a mask, and minimize movement to reduce particulate matter in the air. While this method relies heavily on careful technique, it can be effective for small-scale projects and requires minimal investment beyond the pressure cooker itself.
Lastly, timing and environmental control can play a significant role in cost-effective sterilization. Choose a time of day when the air is calm, and dust levels are low, such as early morning or after rain. Keep windows closed and use an air purifier with a HEPA filter in the room to reduce airborne contaminants. Combine this with working quickly and efficiently during the inoculation process to minimize exposure to the environment. While not foolproof, this approach leverages natural conditions and affordable tools to create a more sterile workspace without the need for expensive equipment.
By exploring these cost-effective solutions, you can successfully create mushroom petri dishes without a laminar flow hood. Each method requires careful planning and attention to detail, but with practice, you can achieve consistent results while staying within your budget. Whether you opt for a DIY glove box, a still-air setup, or environmental controls, the key is to prioritize sterility and adapt the technique to your available resources.
The Magic of Bell Mushrooms
You may want to see also
Explore related products

Contamination Risks Without Hood
When creating mushroom petri dishes without a laminar flow hood, the risk of contamination significantly increases due to the lack of a controlled, sterile environment. A laminar flow hood works by creating a unidirectional stream of filtered air, which helps to displace particulate matter and prevent airborne contaminants from settling on your work surface. Without this protective barrier, your petri dishes are exposed to the ambient air in your workspace, which is likely teeming with spores, bacteria, and other microorganisms. These contaminants can easily settle on the agar surface, competing with your mushroom mycelium for nutrients and potentially leading to failed cultures.
One of the primary contamination risks without a hood is the presence of airborne spores from mold, bacteria, and other fungi. These spores are ubiquitous in indoor environments and can be stirred up by simple movements like opening a window, walking around, or even breathing. When you expose your petri dishes to the open air during inoculation, these spores can land on the agar and begin to grow, outcompeting your mushroom mycelium. Mold, in particular, is a common issue and can quickly take over a petri dish, rendering it useless for mushroom cultivation.
Another significant risk is the introduction of contaminants from your hands, tools, and work surface. Without the sterile environment provided by a laminar flow hood, it becomes crucial to maintain strict aseptic technique. However, even with meticulous cleaning and sterilization, it’s nearly impossible to eliminate all potential sources of contamination in an open environment. Dust particles, skin cells, and other debris can easily transfer from your hands or tools to the petri dish, introducing unwanted microorganisms that can compromise your culture.
The lack of a hood also increases the risk of cross-contamination between cultures. If you’re working with multiple mushroom species or strains, the open air allows for the easy transfer of spores or mycelium fragments between petri dishes. This can lead to mixed cultures or the unintended introduction of competing organisms, which can hinder the growth of your desired mushroom species. Cross-contamination is particularly problematic for beginners who may not yet have the experience to identify early signs of contamination.
Finally, without a laminar flow hood, the success of your mushroom petri dishes becomes heavily dependent on external factors such as room cleanliness, humidity, and air quality. Even a seemingly clean room can harbor hidden contaminants, and fluctuations in humidity or temperature can create conditions favorable for unwanted microbial growth. While it’s possible to create mushroom petri dishes without a hood, the risks of contamination are substantially higher, and the process requires extreme caution, patience, and often multiple attempts to achieve successful, uncontaminated cultures. Investing in a laminar flow hood, even a DIY version, can dramatically improve your chances of success by providing a controlled, sterile environment for inoculation.
Mushroom Coffee: A Natural Energy Boost Without the Jitters
You may want to see also

Essential Equipment Checklist
When creating mushroom petri dishes, a sterile environment is crucial to prevent contamination from bacteria, mold, or other microorganisms. One of the most debated pieces of equipment in this process is the laminar flow hood. While it is highly recommended, it is not strictly mandatory for beginners or small-scale cultivators. However, its absence significantly increases the risk of contamination. Below is an Essential Equipment Checklist tailored to the question of whether a hood is necessary and what alternatives or additional tools can be used.
Laminar Flow Hood (Optional but Highly Recommended):
A laminar flow hood creates a sterile airflow, reducing the risk of airborne contaminants settling on your petri dishes. If you’re serious about mushroom cultivation or working with sensitive strains, investing in a hood is essential. For hobbyists or those on a budget, working in a still air box or glove box can be a temporary solution. These DIY alternatives provide a controlled environment but lack the sterile airflow of a hood. If you choose to forgo a hood, ensure your workspace is meticulously clean, and consider working during times when air particulate matter is minimal, such as early morning or in a closed, clean room.
Sterilized Petri Dishes and Agar:
Petri dishes are the foundation of your mushroom cultivation. Ensure they are sterilized and made of high-quality materials to prevent cracks or leaks. Agar, the growth medium, must also be sterile. You can purchase pre-sterilized petri dishes or sterilize them yourself using an autoclave or pressure cooker. If you’re not using a hood, it’s even more critical to ensure all materials are thoroughly sterilized to minimize contamination risks.
Inoculation Tools:
You’ll need sterilized scalpels, needles, or inoculation loops to transfer mushroom spores or mycelium to the petri dishes. Flame sterilization using an alcohol lamp or cremateur is a common method if you don’t have a hood. Ensure your hands are clean, and consider wearing sterile gloves to reduce the introduction of contaminants. Without a hood, work quickly and confidently to minimize exposure to the environment.
Clean Workspace and Disinfectants:
If you’re not using a hood, your workspace must be spotless. Clean all surfaces with 70% isopropyl alcohol or another suitable disinfectant. Cover your work area with a sterile drape or clean cloth to reduce airborne particles. Work in an area with minimal foot traffic and avoid drafts that could introduce contaminants. A HEPA filter in the room can also help reduce airborne particles.
Alternative Sterilization Methods:
Without a hood, you’ll need to rely on flame sterilization and proper technique to maintain sterility. Practice good aseptic technique, such as working near an open flame to create a sterile field. Additionally, consider using a pressure cooker or autoclave to sterilize your agar and equipment thoroughly. If you’re using a still air box, ensure it’s cleaned and disinfected before each use.
Monitoring and Storage:
After inoculation, store your petri dishes in a clean, dark, and temperature-controlled environment. Monitor them regularly for signs of contamination. If you notice any mold or discoloration, discard the dish immediately to prevent cross-contamination. Label your dishes with the date and spore strain for easy tracking.
In conclusion, while a laminar flow hood is not strictly necessary for creating mushroom petri dishes, it significantly reduces the risk of contamination. If you choose to work without one, invest time in perfecting your sterile technique, workspace cleanliness, and alternative sterilization methods. The success of your mushroom cultivation depends heavily on maintaining a contaminant-free environment, whether you use a hood or not.
Ending a Mushroom Trip: Strategies for Halting Psychedelic Experiences
You may want to see also
Frequently asked questions
While a laminar flow hood is not strictly necessary, it significantly reduces the risk of contamination by creating a sterile environment. Beginners can use alternative methods like the glove box or still air box technique, but a hood is highly recommended for consistent results.
Yes, you can create mushroom petri dishes without a hood by using a pressure cooker for sterilization and practicing good sterile technique, such as working in a clean environment and using a flame to sterilize tools. However, contamination risk is higher without a hood.
Alternatives include using a still air box (SAB) or glove box, which are DIY setups that provide a semi-sterile workspace. Another option is working near an open flame to create a sterile field, though this requires careful technique and practice.
For small-scale cultivators, a hood may not be essential, but it becomes more valuable as you scale up or aim for higher success rates. If you plan to cultivate mushrooms regularly, investing in a laminar flow hood can save time and reduce frustration caused by contamination.

























